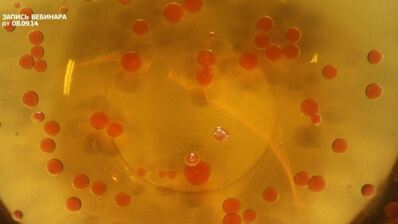
мусс из куриной печенки с икрой из морса

Мусс из куриной печенки с икрой из морса
Грачикова Люля 15 Видео рецепт
За основу был взят рецепт мусса иза яблока. Благодарю автора за прекрасные рецепты.

Рецепт мусса иза куриной печенок с икроя иза морсы
Всегда стараюсь приготовить что-нибудь новое. Недавно пробовала мусс йогуртовый. Рекомендую! Может кому и пригодится.
- Время: 30 мин
- Порций: 6
- Калорий: 213 ккал
- Кухня: Домашняя
- Рецепт: Простой
- Рейтинг:
Ингредиенты:
- печёнка куриная — 100 г
- лук репчатый — 2 шт.
- морковь — 1 шт.
- сливки — 100 мл
- коньяк — 20 мл
- масло оливковое — 300 мл
- масло сливочное — 10 г
- чеснок — 2 зубчик
- соль
- черный перец
- агар-агар — 5 г
- морс — 50 мл
Инструкция:
-
Заранее ставим в холодильник оливковое масло. Разогреваем сотейник с добавлением оливкового масла. Выкладываем морковь и лук. Обжариваем до золотистого цвета. Добавляем измельченные зубчики чеснока. Вливаем коньяк. Фламбируем.
-
2. Добавляем куриную печень. Обжариваем в течение трех минут. Все время помешиваем. Посолим и поперчим.

-
3. Вливаем сливки в печенку. Доводим до консистенции сметаны. Посолим. Измельчаем блендером.

-
4. Готовим икру. Вливаем в отдельный сотейник морс. Добавляем агар-агар. Перемешиваем. Нагреваем.

-
5. Наливаем в миску охлажденное оливковое масло. Как только начнет закипать морс, снимаем с огня. Кладем куриный мусс в банку. Украшаем базиликом.

-
6. Добавляем еще немного агар-агара в морс. Набираем морс в шприц. Капаем в охлажденное масло.

-
7. Откидываем икру через сито. Выкладываем на куриный мусс. Приятного аппетита!

Видео приготовления мусса иза куриной печенок с икроя иза морсы

Мусс
Свекольный мусс
Мусс
Тыквенный мусс
Мусс
Лаймовый мусс с фото

Комментарии к рецепту
Приготовила мусс из куриной печенки с икрой из морса!
Очень вкусно, всем понравилось!
Необычно, но так легко готовится!
Спасибо большое!
Очень вкусно!
Все как в рецепте Грачикова.
Ничего не заменяю,не добавляю)))
Очень быстрый, не хлопотный и вкуснейшие рецептик.
Спасибо огромное за рецептик!!!! Попробуйте http://domreceptum.ru/deserty/muss/muss-amaretto.
Кому посчастливилось отведать мусс из куриной печенки с икрой из морса — все хвалили.
Главное, что просто в изготовлении — не занимает много времени.
Бесподобный рецепт мусса из куриной печенки с икрой из морса!!!
Все получилось, спасибо, Грачикова!!!
Спасибо за рецепт, зайду к вам ещё раз.
Обязательно приготовлю на днях
Спасибо за прекрасный рецепт.
Очень красиво и вкусно!
Спасибо за рецепт…вкуснятина)))
Самый лучший сайт с рецептами из всех, какие я встречала!
спасибо Вам за рецепты с фото!
Спасибочки Грачикова
попробуем обязательно
Дорогая Грачикова!!!
Приготовила мусс из куриной печенки с икрой из морса мужу на ДР, все гости были в восторге и муж в особенности!
Спасибо вам от всех!, а от меня отдельное спасибо за объяснение приготовления.
Грачикова, спасибо Вам огромное за такой замечательный и простой рецепт!
Приготовила второй раз за неделю:)
Все, кто успел попробовать в восторге:)
С обнаружением сайта появилось больше желания готовить!
Хочется перепробовать все рецепты:)
Долго присматривалась к этому рецепту, а сегодня решилась приготовить.
Получила массу удовольствия уже от самого процесса, надеюсь, что и результат превзойдет все ожидания.